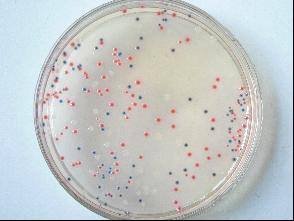

在生物實驗活動之中通過合理的方式實現各種細胞的研究,能夠讓我國現今的生物技術得到更好的提升和保障,而大規模的動物細胞培養活動技術逐步精進和轉基因技術的各種科研項目的快速發展,讓這種動物細胞培養擁有了更好的價值,根據分析動物細胞培養的實驗價值大致有如下幾種:
首先,能夠提升我國現代化生物研究的技術。
眾所周知良好的生物研究技術能夠滿足臨床的需要,并且為疾病的解決帶來更好的參照,而通過服務一流的動物細胞培養方法能夠很大程度上提高現在生物體系的了解程度,獲得更高品質的實用價值,通過動物細胞培養的方式來了解精進我國生物研究技術,以更好的細胞工程作為基礎讓我國生物藥物的研究擁有更好的保障,以此作為基礎也能夠為我國各種實驗技術帶來更好的效果;
其次,能夠提高現代化醫療價值保證更好的應用前景。
通過動物細胞培養的方式來了解生物內部的獨特運作才能夠對治療藥物的選擇和藥物治療方法的改進帶來更好的幫助,通過頂尖的動物細胞培養無疑提升了現如今的醫療效果也更加實質性的醫療水準作為基礎,讓我國醫護水平得到了更好的發展,以此作為基礎也能夠為我國醫藥學的高端研究帶來更好的保障;
總而言之,動物細胞培養作為生物制藥和細胞工程之中極為重要的一大環節,其本身的實驗品質和實驗價值受到了我國許多科研人員的重視,而構建合理的環境采用優質的原材料讓這種動物細胞培養的效率得到提升,也是現今臨床醫療治愈之中不可或缺的一種手段,而借助這種動物細胞培養的方法保證更好的細胞工程建設也有著非同凡響的意義。